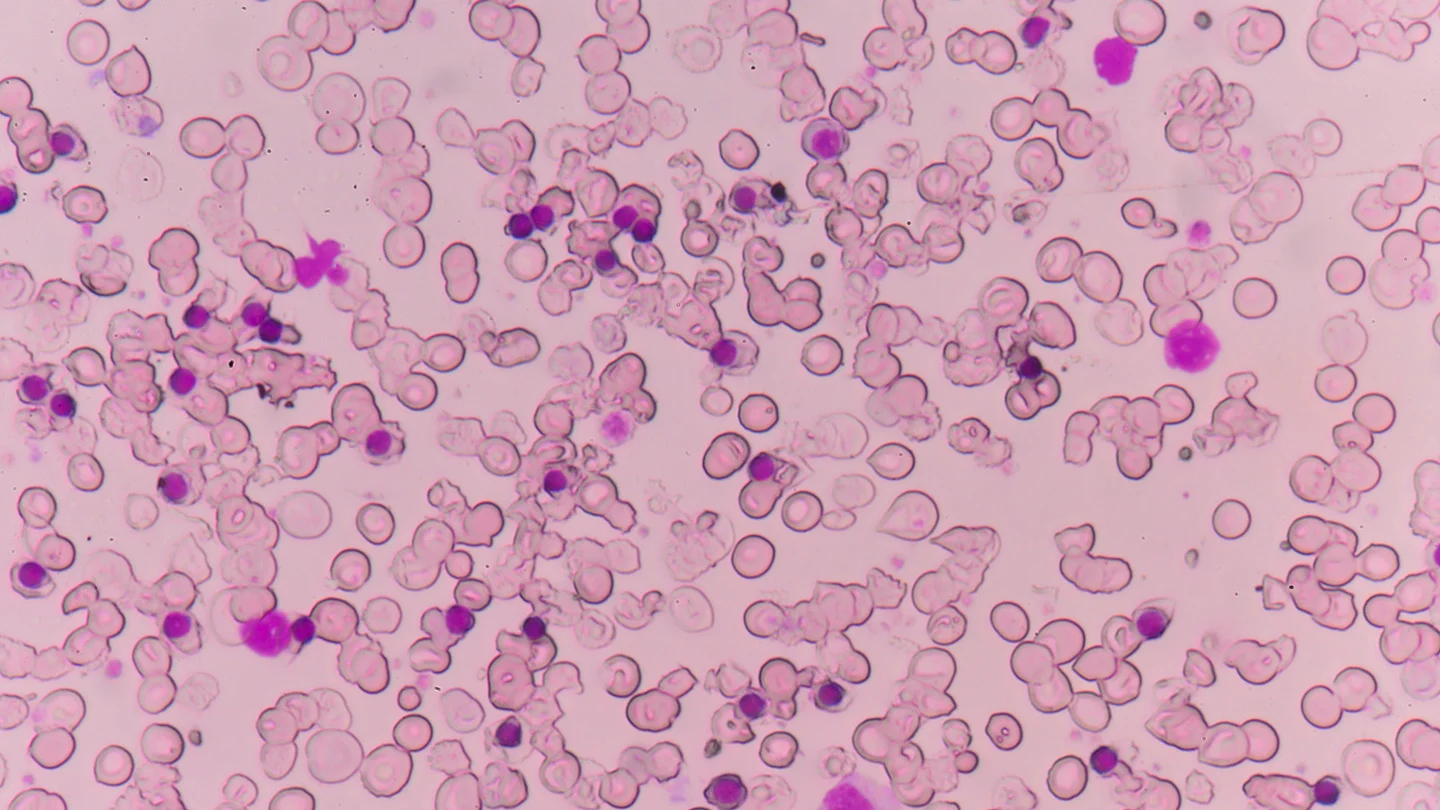

Fetal Treatment Center
On this page
Get care
Why choose UCSF Health for fetal treatments?
Families all over the world travel to UCSF Health for innovative fetal treatments. We care for babies while they are still in the womb, helping diagnose, manage or treat conditions affecting babies before they are born.
As the first fetal treatment center in the country, UCSF Health has the expertise and experience needed to treat complex fetal conditions. We help you navigate treatment options and create a comprehensive, personalized plan for you and your baby.
Our providers lead fetal treatment research, pioneering clinical trials and new fetal therapies. You may be able to join these clinical trials, helping advance fetal medicine and improve care for developing children.
Why choose UCSF Health for fetal treatments?
Families all over the world travel to UCSF Health for innovative fetal treatments. We care for babies while they are still in the womb, helping diagnose, manage or treat conditions affecting babies before they are born.
As the first fetal treatment center in the country, UCSF Health has the expertise and experience needed to treat complex fetal conditions. We help you navigate treatment options and create a comprehensive, personalized plan for you and your baby.
Our providers lead fetal treatment research, pioneering clinical trials and new fetal therapies. You may be able to join these clinical trials, helping advance fetal medicine and improve care for developing children.
Get care
Established program
We performed the world's first successful open fetal surgery and were the nation's first fetal treatment center, giving us a depth of expertise.Team approach
A team of nearly 50 specialists collaborates on fetal treatment plans, giving you comprehensive care recommendations.Innovative fetal treatments
We offer advanced therapies, such as fetal stem cell therapy, whole genome sequencing and fetal endoscopic surgery.Advancing fetal therapy
We've pioneered fetal surgery techniques and participated in or led every fetal treatment study sponsored by the National Institutes of Health (NIH).
Fetal treatment services
Our fetal treatment program is one of the few in the nation with the expertise and experience to handle complex cases. We help babies before birth, working with families to diagnose, manage and treat fetal conditions.
We may recommend prenatal diagnostic testing to evaluate and monitor your baby. A nurse concierge seamlessly coordinates your care, helping you navigate next steps and providing support throughout the process.
To improve long-term outcomes for your baby, we may recommend:
Whole genome sequencing
As the most comprehensive genetic test available, whole genome sequencing can quickly detect rare genetic conditions. A diagnosis helps guide you and your provider as you make care decisions for your baby.
UCSF Health is one of the few hospitals in the country to offer this advanced genetic test.
Fetal stem cell therapy
Our experts can treat some fetal conditions with stem cells.
Fetal image-guided surgery (FIGS-IT)
Using ultrasound imaging, we guide instruments through small incisions in your abdomen and into the womb. Using FIGS-IT, our fetal surgeons can place shunts (small tubes) to drain excess fluid affecting your baby.
Fetal endoscopic surgery (Fetendo)
Fetendo is a less invasive option compared with open fetal surgery. Your surgeon inserts tiny cameras and surgical instruments through small incisions in your abdomen and uterus. They use the instruments to treat your baby and then close your abdomen. Your baby remains in your uterus to continue growing.
We often recommend this approach to treat twin-to-twin transfusion syndrome.
Open fetal therapy
Our experienced surgeons make an incision in your abdomen and uterus to reach your baby. We perform surgery on the baby and then close the incision. Your baby remains in your uterus to continue growing.
Open fetal therapy often improves the outcomes for babies with spina bifida or large tumors.
Locations
Providers

Hanmin Lee, MD
Pediatric General Surgery • General Surgery
Mary E. Norton, MD
Maternal and Fetal Medicine • Clinical Genetics
James Anderson Jr., MD
Neonatology
Karla Bermudez Wagner, MD
Obstetrics and Gynecology • Maternal and Fetal Medicine
Recognized Excellence
10,000+
families treated from all 50 states and dozens of countries
#1
in number of fetal surgery clinical trials

One of the nation’s best for obstetrics & gynecology
Related conditions & treatments
Conditions
- Agenesis of the Corpus Callosum
- Amniotic Band Syndrome
- Bronchopulmonary Sequestration
- Congenital Diaphragmatic Hernia (CDH)
- Congenital Heart Disease
- Congenital High Airway Obstruction Syndrome
- Congenital Pulmonary Airway Malformation
- Gastroschisis
- Neonatal Bowel Obstruction
Treatments
- Fetal Surgery
- Whole Genome Sequencing
Clinical trials
Registry of Patients Diagnosed With Lysosomal Storage DiseasesOpens in a new window
Prenatal presentation of symptoms (e.g. hydrops) appearing on fetal imaging such as ultrasound and ECHO.International Registry of Patients With Alpha ThalassemiaOpens in a new window
Number of fetuses diagnosed with alpha thalassemia who survive to birth, compared to number of fetuses diagnosed with alpha thalassemia who have fetal demise or are terminated in utero. This is measured in number of fetuses alive...PEARL (PrEnAtal Enzyme Replacement Therapy for Lysosomal Storage Disorders)Opens in a new window
Adverse and serious adverse events including, but not limited to, death within 24 hours after the procedure, stillbirth, death prior to initial hospital discharge,increased response with antibody development above that expected wi...A Single-Stage, Adaptive, Open-label, Dose Escalation Safety and Efficacy Study of AADC Deficie...Opens in a new window
Assessment of adverse events related to surgery (including intracerebral hemorrhage or stroke, CNS infection) and gene transfer (including severity of post-operative dyskinesia)DECIDE: A Comparative Effectiveness Trial of Metformin Versus Insulin for the Treatment of Gest...Opens in a new window
LGA will be defined as a birthweight ≥90th%tile for gestational age based on a US birth certificate reference adjusted for parity and/or fetal sex. Neonatal hypoglycemia will be defined as a blood glucose <35 mg/dL or treatment <2...Effectiveness of Two Aspirin Doses for Prevention of Hypertensive Disorders of Pregnancy: ASPIR...Opens in a new window
HDP defined as preeclampsia or antepartum gHTN based on ACOG criteriaGenomic Sequencing in Anatomically Normal FetusesOpens in a new window
Proportion of positive genetic diagnosis among all pregnancies with anatomically normal fetusesCommercial or Open Source Closed Loop Impact on Pregnancy StudyOpens in a new window
Primary neonatal outcome. LGA defined as birth weight > 90th percentile for gestational ageSlow Heart Registry of Fetal Immune-mediated High Degree Heart BlockOpens in a new window
Few studies are specifically designed to address health concerns that are already relevant during pregnancy. The consequence is a lack of evidence on best clinical practice.Surveillance and Treatment to Prevent Fetal Atrioventricular Block Likely to Occur Quickly (STO...Opens in a new window
The presence of NR (normal rhythm) will be determined by electrocardiogram (ECG)
Research initiatives
UCSF Fetal Treatment Center ResearchOpens in a new window
Since its founding, the UCSF Fetal Treatment Center has been on the forefront of fetal therapy research. Together, researchers and doctors from many disciplines work to improve options for the smallest patients.
Explore what we do
Healing a body, even before birth

Fetal therapy for lysosomal storage diseases

Birth of a procedure

Life-changing fetal therapy for thalassemia
Special programs
Meet our providers
Hear from our providers about how they center the needs of patients and families in their work.
1 of 7
Cutting-edge research
Our experts have led or participated in every fetal treatment study sponsored by the National Institutes of Health. This pioneering research includes clinical trials of promising new therapies and supports the advanced care we provide.Maternal-fetal precision medicine


Clinical trial: In utero enzyme replacement therapy
Clinical trial: Alpha thalassemia


















